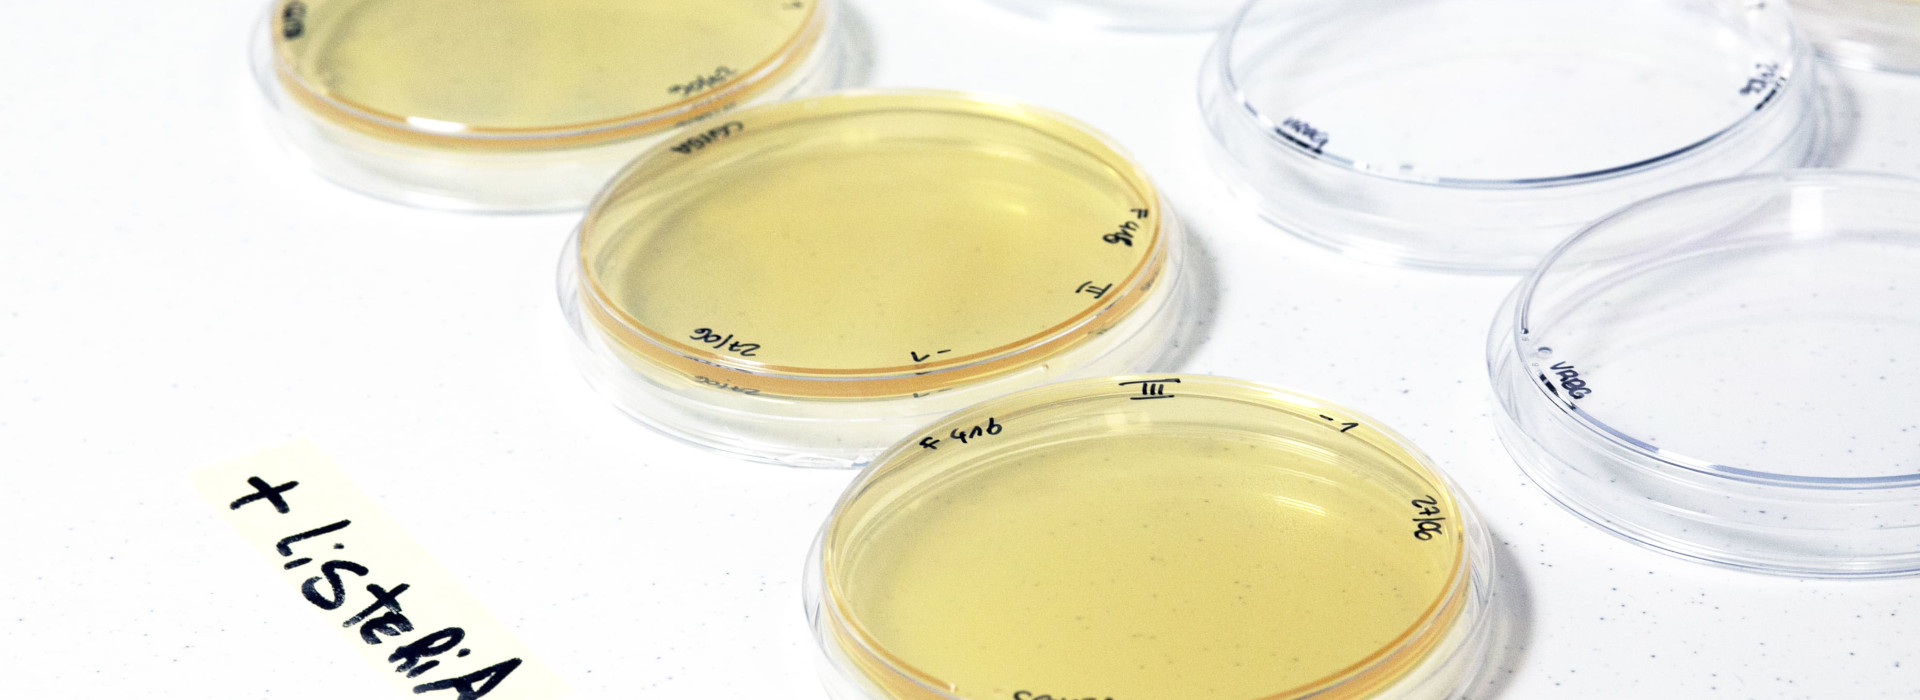

Sicurezza alimentare: il controllo microbiologico delle superfici
Le superfici degli ambienti confinati come le superfici degli impianti, delle attrezzature e degli utensili sono sempre soggette a contaminazioni microbiche, a loro volta trasferibili ad oggetti terzi.
Per debellare le contaminazioni, possono essere necessari diversi livelli di pulizia delle superfici: può essere necessario operare una vera e propria sterilizzazione (settore ospedaliero, camere bianche), ma nel settore alimentare normalmente è sufficiente ridurre la carica microbica a valori “accettabili”, che significa non pericolosi per le produzioni con cui vengono a contatto.
Superfici e sicurezza alimentare: perché serve il monitoraggio
Si chiamano biofilm microbici e sono vere e proprie “pellicole” : un insieme di cellule batteriche adese alle superfici e inglobate in una matrice polisaccaridica secreta dalle cellule stesse.
I biofilm consentono ai batteri di sopravvivere in ambienti sfavorevoli e a stress ambientali quali variazioni di temperatura, essiccamento, raggi ultravioletti, interventi di sanificazione e ciò ancor più se le superfici non sono lisce e integre, ma porose, rugose e con fessure, abrasioni e corrosioni, che costituiscono “nicchie” di protezione delle cellule.
Infatti, una direttiva europea del 2006 (“Direttiva macchine”) indica che tutte le superfici a contatto con i prodotti alimentari, cosmetici o farmaceutici devono essere lisce e prive di rugosità o spazi in cui possano fermarsi materie organiche, essere progettate e costruite in modo da ridurre al minimo le sporgenze, i bordi e gli angoli e devono poter essere pulite e disinfettate facilmente, dopo aver asportato le parti smontabili.
Sicurezza alimentare: le analisi microbiologiche
Per valutare le condizioni igieniche delle superfici è necessario, dopo un’attenta analisi microbiologica, un processo operativo che può essere gestito in due modi.
Il metodo classico del “tampone” utilizza generalmente un’asticciola in plastica con un’estremità in ovatta, inserita in una provetta con un terreno di trasporto (o di mantenimento o di arricchimento).
La punta del tampone viene inumidita nella soluzione contenuta nella provetta, quindi si effettua il campionamento strisciandola sulla superficie in esame per almeno 30”, facendola ruotare a ogni cambio di direzione, per assicurare un migliore recupero di microrganismi; il tampone viene poi inserito nella provetta scartando la parte che è stata toccata dall’operatore.
Analogo è l’utilizzo delle “spugnette” (“Sponge bag”) disidratate che vengono reidratate al momento dell’esecuzione dell’analisi con soluzione fisiologica o con terreni di prearricchimento specifici per i microrganismi che si desidera ricercare.
La spugna umidificata viene strisciata da entrambi i lati sulla superficie in esame, quindi reintrodotta asetticamente nel suo contenitore e trasportata in laboratorio per l’analisi microbiologica.
Questo metodo è consigliato per il monitoraggio di superfici ampie, disomogenee e irregolari, poiché la spugna è morbida e pieghevole.